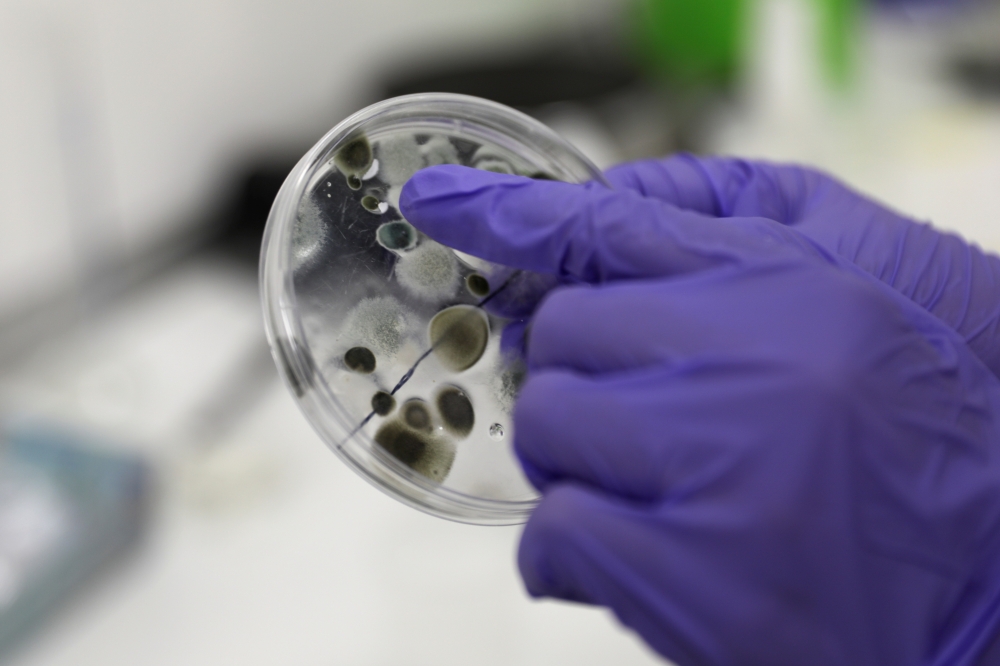
Employee at Science4you factory shows the result of an experiment of the Antivirus Lab science toy, in Lisbon, Portugal, December 2, 2020. Picture taken December 2, 2020. REUTERS/Pedro Nunes

Employee at Science4you factory shows the result of an experiment of the Antivirus Lab science toy, in Lisbon, Portugal, December 2, 2020. Picture taken December 2, 2020. REUTERS/Pedro Nunes
MADRID/LISBON: Children in Spain and Portugal could find that their Christmas presents this year reflect the coronavirus pandemic as dolls wearing face masks, kits for making personal protection items, and other toys adapted to fit the times fly off shop shelves.
Millions of kids around the world were stuck in their homes during a series of lockdowns, and when they did emerge, they were often told to wear masks.
So, as the holiday season approached, some toymakers gave their toys a twist.
"I think it's a way of adapting to reality," said mum Reyes Lopez as she looked around a toy store in Madrid. "Dolls also have to represent society."
In the shop, some of Spanish toymaker Famosa's popular Nancy dolls were wearing a protective mask. Another set of dolls came with a virus tester which can detect if the toy is "infected". If it is, the child can cure it by tickling it.
"Putting a mask on their dolls helps (kids) realise they need to wear one themselves," shopper Cristina Hernandez said.
Shop manager Adela Haro said the COVID-19-related toys were selling well, while Famosa CEO Marie-Eve Rougeot told Reuters the mask-wearing doll had been a hit since went on sale in September.
"When children face going to the doctor or having a test, they will be less anxious," Rougeot said of the toys.
In neighbouring Portugal, firm Science4You said sales of its toys related to the virus were booming, especially online as people stayed away from big shopping malls due to fear of contagion.
One of the toymaker's top hits is a kit of 15 activities that include making masks, face shields and star-shaped soap.
"If we make it fun, children will learn much more about the virus and how to keep away from it," Science4You's chief executive Miguel Pina Martins said as he pointed at the anti-virus lab package, which costs around 20 euros.
The innovations are also a way for toy makers to adapt to the economic impact of the pandemic.
"The toy market is going through a difficult time...there are no birthday parties since March," Pina said. "We tried to find a way to surf this giant tsunami."
Science4You said they had sold more than 8,000 anti-virus lab kits since it came on the market in mid-July.
Though studies have showed that children are less likely than adults to get severe cases of COVID-19 infection, they can still carry the virus.




